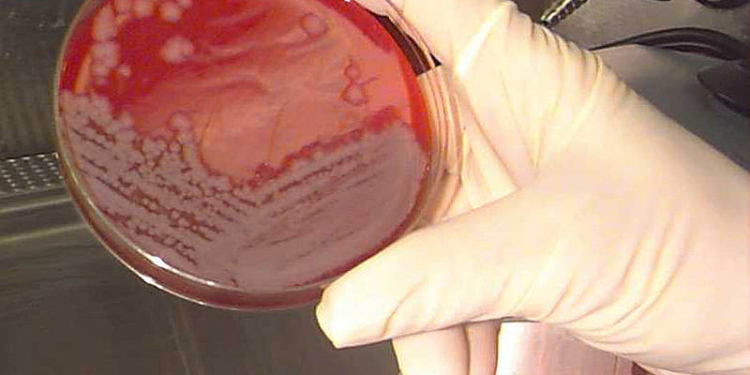
Военные США по ошибке разослали споры сибирской язвы

Існує багато доказів того, що Росія застосовує проти ЗСУ на фронті хімічну зброю. Однак цілком можливо, росіяни готуються до застосування біологічної зброї.
Як пише The Washington Post, супутникові знімки MAXAR і Planet Labs зафіксували будівництво під Москвою спеціалізованого лабораторного комплексу, призначеного для дослідження й обробки смертельних патогенів.
Видання зазначає, що місце розташування нового комплексу – Сергієв Посад-6, яке під час Холодної війни було великим дослідницьким центром біологічної зброї, з історією експериментів із вірусами, що викликають віспу, Еболу та геморагічні лихоманки.
Тепер же на супутникових знімках видно не тільки ремонт старої лабораторії, а й будівництво 10 нових будівель загальною площею понад 250 000 квадратних футів, причому деякі з них мають чіткі ознаки біологічних лабораторій, призначених для роботи з надзвичайно небезпечними патогенами.



Як зазначає WP, при цьому на супутникових знімках розчищення території стає помітним у травні 2022 року, за кілька місяців після початку повномасштабного вторгнення Росії в Україну і приблизно під час очолюваної Кремлем кампанії з дезінформації, в якій США звинувачували в допомозі Києву у створенні секретної програми біологічної зброї.
На знімках також видно численні ознаки, які в сукупності вказують на біологічний об’єкт із високим ступенем захисту: десятки установок для обробки повітря на даху, відповідне планування, підземна інфраструктура, підвищені заходи безпеки і електростанція.
При цьому представники розвідки та експерти з біологічного захисту кажуть, що за супутниковими фотографіями неможливо визначити, чи планує Росія проводити дослідження в галузі наступальної біологічної зброї. Лабораторія, обладнана для вивчення смертельного вірусу Ебола з метою розроблення вакцини, може зовні виглядати ідентичною до тієї, яка проводить дослідження з перетворення штаму на зброю.
Крім того, заходи з безпеки навколо об’єкта включають у себе контрольно-пропускні пункти, проєктування доріг, розчищення дерев і додаткові огорожі, які жорстко контролюють рух і дають змогу здійснювати моніторинг і спостереження. Такі запобіжні заходи зазвичай прийняті на об’єктах підвищеної секретності, пише WP.
Сергієв Посад-6 – один із трьох російських збройових об’єктів, які ніколи не надавали доступ міжнародним експертам. Аналітики американської розвідки дійшли висновку, що на об’єкті, ймовірно, все ще зберігаються заморожені колекції вірусів, які вивчалися і тестувалися за радянських часів.
За інформацією радянських учених, які емігрували на Захід, останніми роками в СРСР вчені намагалися вирощувати нові штами бактерій чуми, які були генетично модифіковані для підвищення стійкості до антибіотиків. І, на думку експертів, адміністратори Сергієва Посада-6 розглядають можливість експериментів зі штучними штамами.
Нагадаємо, через біологічну зброю США ввели санкції щодо трьох російських НДІ